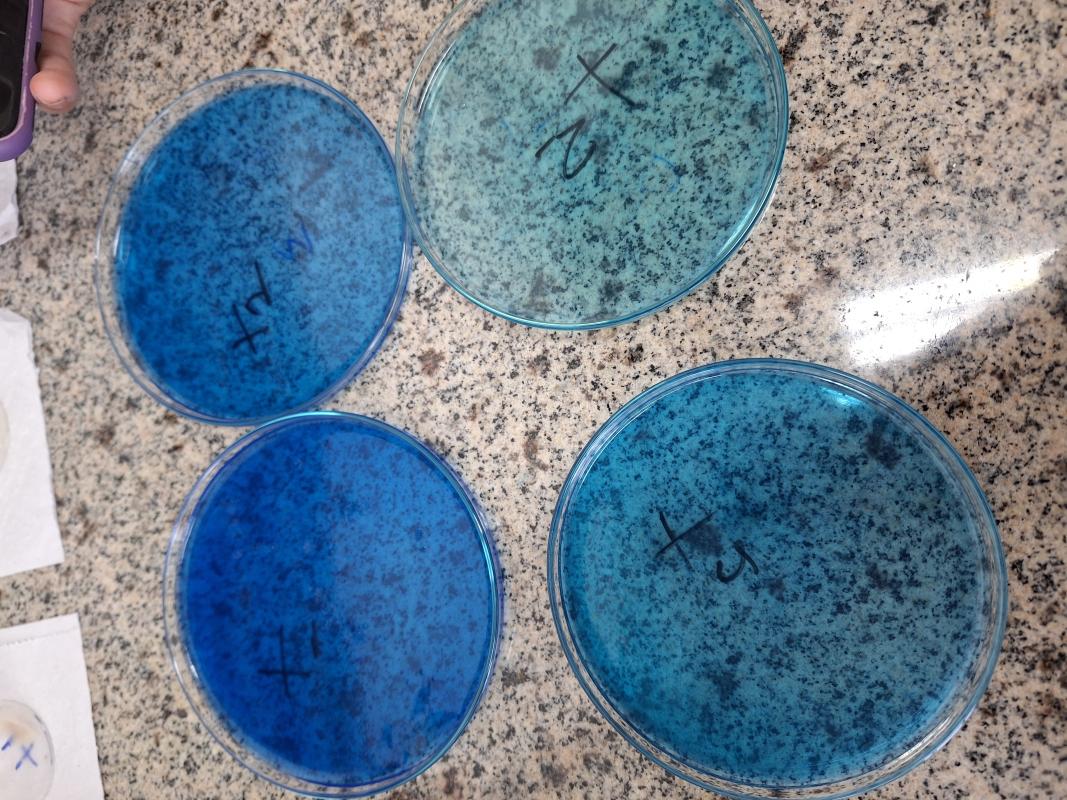
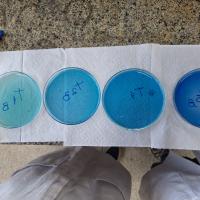

Biofilme de algas marinhas
A motivação do projeto são os alarmantes dados sobre os impactos do plástico no meio ambiente e a vontade de mudar esse cenário.
Foram feitas pesquisas e testes em laboratório, sob orientação de uma professora, os materiais utilizados são de baixo custo e fácil acesso, sendo eles ágar ágar, polissorbato 20 e glicerina.
Após varios testes, o resultado foi bem semelhante a uma sacola de mercado.
Esses resultados nos levam a pensar se é realmente necessário destruir tanto para produzir objetos que são usados por tão pouco tempo.
O que mais chama atenção é o fato do biofilme se degradar completamente em 2 a 3 meses em condições normais de solo, já as sacolas de mercado demoram até 20 anos.
Alternativas sustentáveis são possíveis, sem perder a qualidade de vida, podemos ser mais conscientes e viver num mundo melhor.